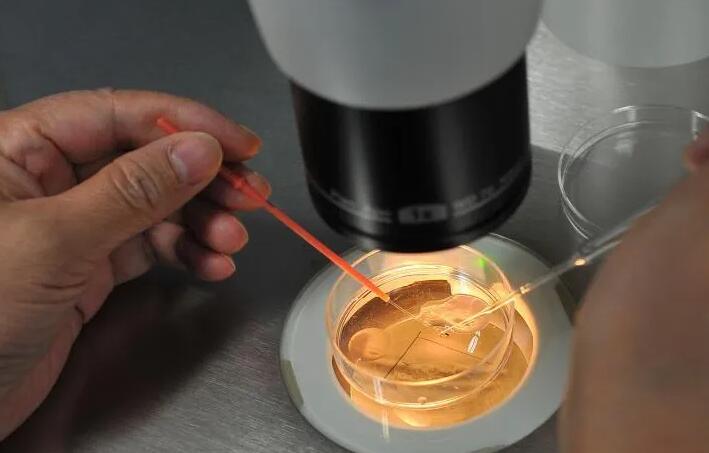
10细胞胚胎养囊成功率高不高？效果怎么样？

-
做试管时的胚胎评分中9细胞和8细胞选哪个好?
我之前是备孕了有3年时间,但是一直没有怀孕,后来检查是老公的输精管堵塞,医生就建议做试管,这样能更快的怀孕,现在我们就是再进行二代试管,我已经取卵完了,在等待移..
2023-03-30 11:24 -

试管婴儿移植前查出nk细胞值太高,自然杀伤细胞危害到底多大?
试管婴儿移植前查出nk细胞值太高,自然杀伤细胞危害到底多大?我以前有多囊卵巢综合征不过吃药调理了一段时间好一些了,所以和家人亲戚都商量了一下支持我们去做试管婴儿,..
2023-04-04 12:35 -
因试管2次未着床检测出nk细胞高,那nk细胞正常值范围是多少呢?
因试管2次未着床检测出nk细胞高,那nk细胞正常值范围是多少呢?由于我有子宫内膜异位症的原因,和我丈夫商量着去做试管怀孕的成功率会高一些,但是做了两次试管都没有正常..
2023-04-08 13:30 -

融合胚胎和8细胞的区别汇总,移植哪个好对比质量就知道
我们都知道,在试管婴儿治疗过程中都是会将在体外形成的胚胎进行等级划分的,实验室的操作人员根据胚胎的细胞数量、碎片率、大小分为四个等级。根据胚胎的质量来看融合胚胎..
2023-04-10 09:26 -
因第三代试管2次未着床检测出nk细胞高,那nk细胞正常值范围是多少呢
因第三代试管2次未着床检测出nk细胞高,那nk细胞正常值范围是多少呢?由于我有子宫内膜异位症的原因,和我丈夫商量着去做第三代试管怀孕的成功率会高一些,但是做了两次第..
2023-04-13 12:42 -
3天6细胞2级胚胎二代试管婴儿胚胎移植成功率高吗?
我今年开始做的试管,今天早上医生就告知我胚胎养好了,是3天6细胞2级胚胎,让我准备好了就去移植。我对胚胎等级不是很了解,之前只听过说什么A级、B级、C级的,没有见过数..
2023-04-18 13:07 -

3天胚胎8、9、10细胞质量对比,哪个好、成功率一文读懂
在试管婴儿的治疗中,受精卵培养的时间一般为3天、5天和6天,我们把培养三天就移植的胚胎称为鲜胚移植,把培养5天或6天的胚胎移植称之为囊胚移植。本文将主要分享鲜胚移植..
2023-04-24 09:05 -

试管移植6细胞鲜胚的成功率高不高,弄清胚胎质量就知道
鲜胚移植的胚胎只发育了三天,一般情况下医生会根据胚胎的生长速度、细胞个数、胚胎碎片以及染色体等因素对细胞分级。6细胞指的是鲜胚中发育了6个细胞,这种胚胎可以划分四..
2023-05-18 10:17 -

解读8细胞和6细胞胚胎的区别,哪个好、移植成功率对比
我们都知道,试管婴儿的成功率会受到多方面因素的影响,除了女性的年龄、宫腔环境、医生技术等方面,胚胎的质量也是非常重要的,胚胎的质量越高,那么移植的成功率就越高,..
2023-05-19 09:05 -

3天9细胞的胚胎质量级别怎么样,从这几方面就能了解
众所周知,胚胎的质量决定着试管婴儿移植的成功率,胚胎的质量等级越高,那么移植的成功率就越高,反之则越低。一般来说,在试管取卵手术完成之后,就需要将男性的精子和取..
2023-06-01 09:49 -

第三天胚胎质量等级一览:细胞大小、碎片率为划分依据
我们都知道,试管婴儿受精的方式是非常不一样的,通常需要通过促排取卵在体外和精子进行结合,最终形成胚胎。而胚胎又分为三天的胚胎和5~6天的囊胚。三天的胚胎由于每个胚..
2023-06-05 09:57 -

卵母细胞成熟障碍能自然怀孕吗?能不能做试管?
卵母细胞成熟障碍能自然怀孕吗?能不能做试管?怀孕是一个系统的过程,需要身体各个器官的配合。体内的激素只有在大脑皮层的控制下才能正常工作。如果你背负着压力,精神一..
2023-06-21 11:10 -

卵母细胞成熟障碍能做试管吗?适合哪个方案?
卵母细胞成熟障碍能做试管吗?适合哪个方案?大家应该都知道,在试管婴儿治疗中,是需要成熟卵子和精子参与的辅助妊娠治疗。因此,获得一定数量的健康成熟卵子是试管婴儿治..
2023-06-21 11:37 -

五细胞胚胎可以移植吗?胚胎移植的标准是什么?
在做试管的时候,很多人要为胚胎移植的事情而烦心,这是避免不了的。特别是当一次做了多个胚胎,要选择去移植哪一个时更是让人纠结。特别是每个胚胎的生长有快有慢,其中有..
2023-06-25 11:30 -
10细胞胚胎养囊成功率高不高?效果怎么样?
10细胞胚胎养囊成功率高不高?效果怎么样?新鲜胚胎和囊胚都有胚胎质量评级标准。比如D3日胚胎评级标准,主要依据第三日胚胎发育速度、卵裂球数量、卵裂球整齐度、胚胎碎片..
2023-08-27 11:51 -

深究引起nk细胞偏高的三大因素,感染或成最大原因
nk细胞是人体内一种自然杀伤细胞,对肿瘤细胞有迅速杀伤和溶解作用。nk细胞偏高是异常情况,可能和感染、疾病因素影响、特殊免疫导致。其中感染性因素最导致nk细胞偏高的常..
2023-08-28 09:24 -

孕妇nk细胞高危害不止一点点,胚胎发育可能因此受影响
NK细胞是人体重要的免疫细胞,在对抗肿瘤和感染时发挥重要作用。这种细胞和人体的免疫力密切相关,NK细胞能够参与超敏反应,会影响自身免疫性疾病的发生。如果孕妇nk细胞偏..
2023-08-29 10:28 -
GV期卵子和MI/MII期卵母细胞的区别是什么
在试管婴儿的治疗过程中,首先会促排一段时间,然后注射HCG(俗称打夜针)后36小时进行取卵,并采用阴道超声引导下经阴道穿刺取卵术从而获得卵子,但并不是每一个卵子都是可..
2024-04-30 09:31 -

体外培养3天的11细胞胚胎是几级胚胎?
单从细胞个数来讲,试管婴儿中第三天的11细胞的胚胎是比较好的,胚胎细胞数量在6-11个左右就都具有较好的发育潜能,可以进行移植,并有一定几率着床成功。但是还需要看冷冻..
2024-05-15 09:54 -

试管婴儿移植一个10细胞1级鲜胚的成功率大吗?
我和老公结婚快3年了,因为双方家长催生比较厉害,我们俩实在是顶不住压力,就踏上了备孕之路,但没想一晃半年过去了,还没怀孕,检查身体后就去做了试管婴儿,目前正在培..
2024-06-10 09:52
微信分享
扫描二维码分享到微信或朋友圈